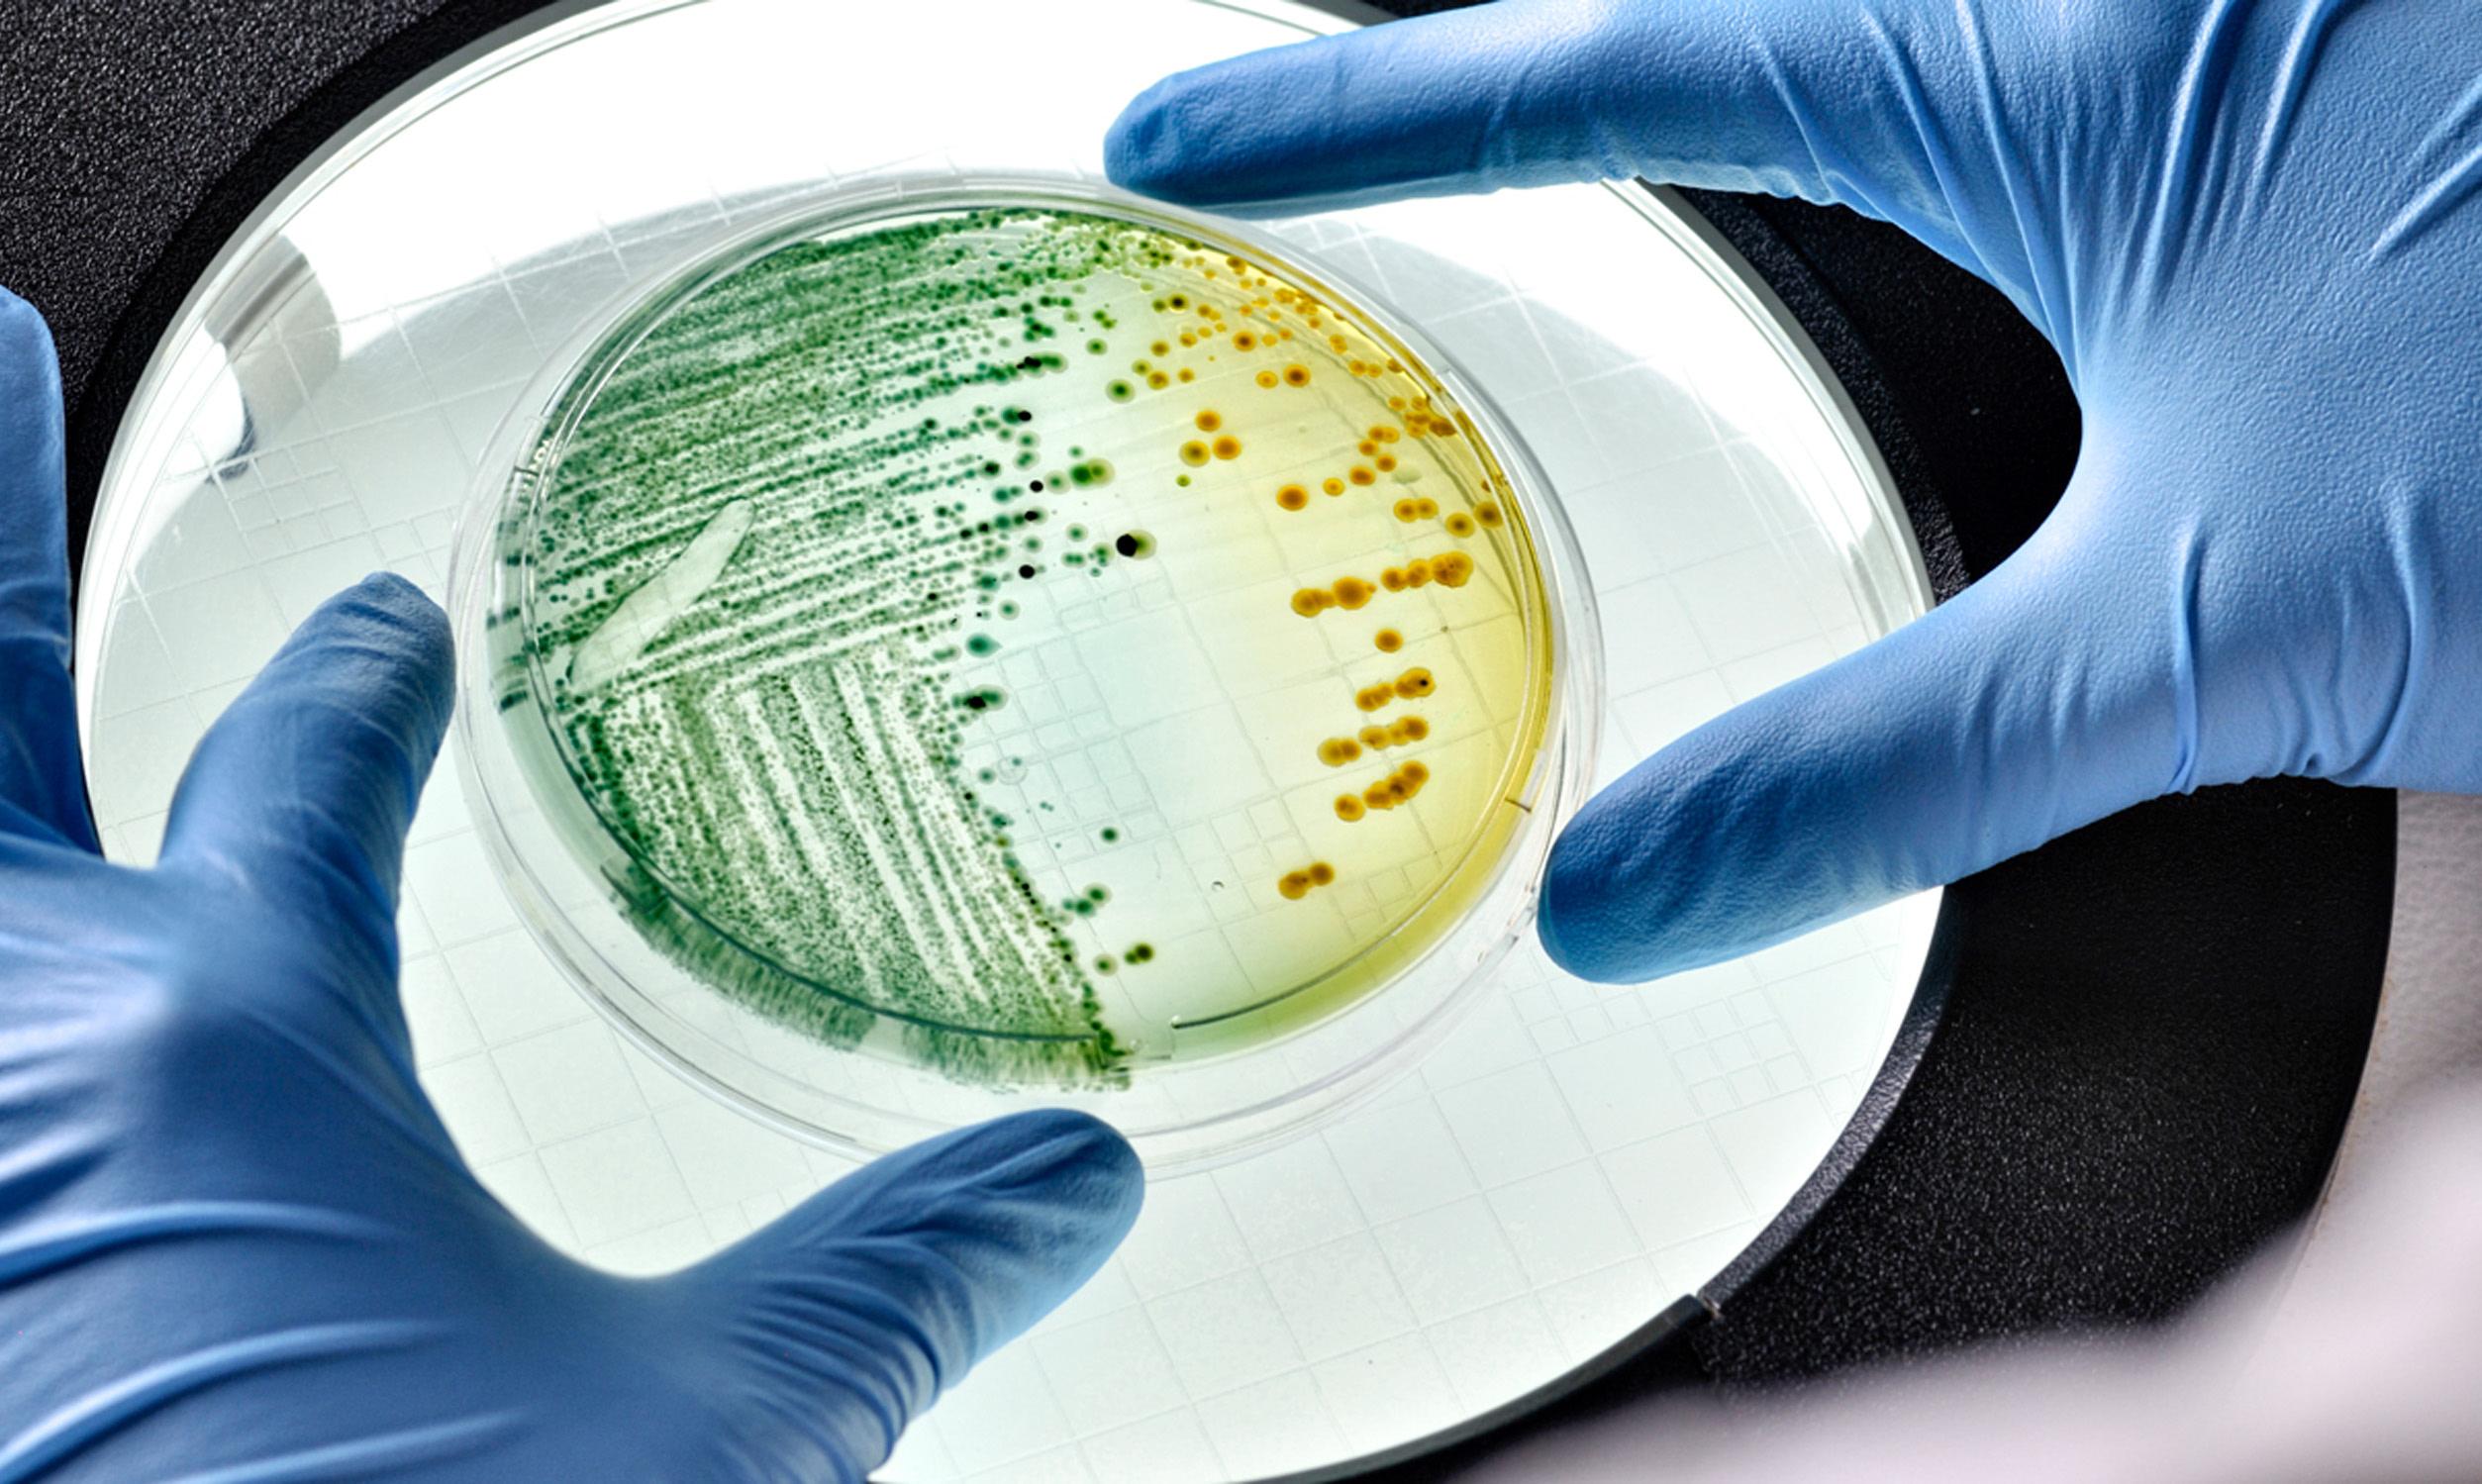

la Bacteria:
Esta bacteria puede producir infección en el tracto urinario, en heridas quirúrgicas (infección nosocomial cuando se produce en el hospital) y bacteriemias (infección en la sangre).
la situaciÓn:



•Son cuatro bebés con la bacteria

•Dos de ellos continúan hospitalizados
•Uno ya falleció
•Uno más ya presentó mejoría
Señalan que ya se inició una investigación y que darán apoyo a los padres del bebé fallecido y atención extraordinaria a los que se mantienen con vida.
no nos dicen de que bacteria se trata -oficialmente-, están poniéndole medicamentos a mi hijo, pero ninguno de ellos ha sido efectivo, ya que no mejora y empeora cada día
opinión de LoS denUnCiAnTeS
Bacteria amenaza cuneros del imss

La Secretaría de Salud Federal (SSA) confirmó la presencia de la bacteria
Enterobacter cloacae en cuatro recién nacidos del hospital del Instituto Mexicano del Seguro Social (IMSS), particularmente en una clínica del municipio de Ciudad Madero, en donde uno de ellos murió.
www.eldiariomx.com domingo 28 de mayo de 2023 edición mx .com Fuente: the Weather Channel HOY 23°/35° Nublado lunes martes 23°/35° 25°/35° Nublado Nublado el clima redacción
ed
AUToridAdeS
opinión de LAS
No llegaba el agua, no pasaba la basura, se inundan, los pavimentos ya no sirven, no hay alumbrado, no hay vigilancia, son muchas las razones por las que los trabajadores abandonan las casas
ROMPE TAMAULIPAS ‘RÉCORD’ EN VIVIENDAS ABANDONADAS
DELEGADO DEL INFONAVIT EN EL ESTADO, HONORIO CORTÁZAR SALAZAR, REVELÓ QUE EN LA ENTIDAD SE TIENE UN REGISTRO DE 485 MIL CASAS QUE FUERON ABANDONADAS
ROGELIO RODRÍGUEZ MENDOZA
El número de casas del Infonavit abandonadas en Tamaulipas rompió récord al llegar a la cifra de 485 mil viviendas, informó Honorio Cortázar Salazar.

El delegado del Infonavit en la entidad
Confían en la reapertura del ingenio de Xicoténcatl
ALFREDO GUEVARA
El cierre del ingenio azucarero de Xicoténcatl –en julio de 2020– ocasionó la deserción de familias de esa población a otras, como la migración de la producción de caña a otros cultivos para poder subsistir, consideró Florentino Aarón Sáenz Cobos.
El expresidente de la Liga de Comunidades Agrarias y Sindicatos Campesinos de Tamaulipas dijo que si bien se amplió el ingenio en Mante para tener una mayor capacidad en la zafra de caña, lo que se requiere es que también la factoría de Xicoténcatl se reactive.
Confirmó pláticas que se han realizado entre el Gobierno federal, la Secretaría del Trabajo y empresarios, con la idea de que la factoría de Xicoténcatl reabra y reanude operaciones, tras considerar que “un ingenio como el de Xico, no debe estar como un monumento a la ineficiencia e irresponsabilidad”.
“Un ingenio genera de seis a ocho meses de zafra, el resto es de sufra, porque viene la reparación por obreros y trabajadores de campo, en la zafra se activa toda la fortaleza”, explicó.
Comentó que la compañía azucarera del
explicó que se trata de viviendas que sus propietarios dejaron de pagar, por diversas razones.
Algunos derechohabientes abandonaron los inmuebles porque ya no pudieron seguir pagándolos al quedarse sin empleo, y otros lo hicieron porque no estaban
satisfechos con los servicios públicos.
“No llegaba el agua, no pasaba la basura, se inundan, los pavimentos ya no sirven, no hay alumbrado, no hay vigilancia, son muchas las razones por las que los trabajadores abandonan las casas”, mencionó.
Ante ello, dijo, el Infonavit realiza el procedimiento administrativo para recuperar legalmente las casas y posteriormente ponerlas a la venta nuevamente.
En ese proceso de venta tendrán prioridad los propietarios, a quienes se les dará la oportunidad de ponerse al corriente con sus pagos.
“Estamos iniciando un proceso para llamar a todas las personas que abandonaron sus viviendas, para preguntarles si les interesa quedarse con ellas, para ver la forma en que las puedan pagar”, detalló. Agotada esa instancia, se pondrán las viviendas a la venta pública.
Continúa dengue a paso lento; 22 casos
JOSÉ DEL CARMEN PERALES RODRÍGUEZ
Al corte del 22 de mayo, Tamaulipas reporta un acumulado de 22 casos de dengue, la mayor parte de estos del tipo no grave de acuerdo con el más reciente reporte de la Dirección General de Epidemiología (DGE) federal.
uno corresponde al tipo tres, en tanto que los restantes seis están todavía en estudio.
En lo que se refiere a casos probables, la DGE informa que se han estudiado 323 casos del uno de enero al 22 de mayo, en tanto que en el mismo lapso, pero del año pasado, solamente habían registra 125 casos probables.
río Guayalejo cerró el ingenio ubicado en la cabecera municipal de Xicoténcatl, como resultado de la adversa situación financiera que venía padeciendo desde hacía varios años y que se agudizó en el 2020, orillando al cierre de la empresa.

Desde julio de 2020 a la fecha, confirmó que muchas familias que se dedicaban a la producción de caña tuvieron que emigrar hacia otras poblaciones por falta de ingreso económico y el golpe a la economía que representó para quienes residen en esos lugares.
“Ojalá y se reactive el ingenio de Xicoténcatl, por la razón y conveniencia de que se necesita esa fuente de empleo y los recursos que genera, porque hay quienes han emigrado a otros cultivos, dejando de lado a lo que durante muchos años se dedicaron, como lo es la producción de caña”, sostuvo.
En lo personal, Sáenz Cobos mostró confianza de que el ingenio azucarero de Xicoténcatl se reactive y permita una recuperación de la economía de esa región, que básicamente vive de la producción de caña y lo que ello genera.
La dependencia precisa que la entidad solamente agregó dos casos nuevos en la última semana epidemiológica, por lo que aún no supera el número de contagios del mismo periodo del año pasado.
La DGE precisa que 14 de los casos corresponden al dengue tipo no grave, mientras que los restantes ocho son del tipo con signos de alerta, al mismo tiempo que reporta que en la entidad circulan tres de los cuatro serotipos identificados en el país.
En ese sentido, precisa que 13 casos corresponden al dengue virus tipo uno, mientras que dos corresponden al tipo dos y solo
En cuanto a la distribución por municipios, se informa que Tampico acumula 12, de los cuales nueve son de tipo no grave y tres con signos de alerta.
Le sigue Madero con seis, divididos cuatro no grave y dos con signos de alerta; y finalmente Altamira con cuatro, de los que uno es no grave y tres con signos de alerta.
En el mismo lapso del año pasado, Tamaulipas acumulaba 26 casos de dengue, por lo que la estadística actual está a solo cuatro de igualarla, sin embargo, aún restan los meses considerados como temporada alta de esa enfermedad.

www.eldiariomx.com DOMINGO 28 de mayo del 2023
LA
HONORIO CORTÁZAR SALAZAR, delegado del Infonavit en Tamaulipas
RAZONES
Chivas vs Tigres




19:35 horas
Estrellas


¡Todonada!o
Chivas y Tigres dejarán Todo en la CanCha en la búsqueda del TíTulo del Torneo Clausura 2023 en la liga MX



Ciudad de MéxiCo -
El primer episodio de la gran final entre Chivas y Tigres del Torneo Clausura 2023, de la Liga MX, terminó en un empate sin anotaciones en el Volcán, pese a los intentos de los regios por perforar las redes, ya que la estrategia rojiblanca funcionó bien al realizar un juego defensivo.




Será el próximo domingo 28 de mayo cuando se defina al nuevo campeón del fútbol mexicano en el Estadio Akron. El Guadalajara busca su treceava estrella mientras la U quiere la
octava. El defensa brasileño Samir Caetano siguió sin ver acción con los regios, aunque sí estuvo en el banquillo, mientras de lado de Chivas se debe recordar que la única baja fue Carlos Cisneros, quien sufrió una lesión de ligamento cruzado que lo alejará de las canchas de seis a ocho meses.
Luego del empate conseguido en el Volcán, el técnico serbio Veljko Paunovic se dijo satisfecho por cumplir el objetivo de no recibir gol, aparte ahora se concentra en recuperar jugadores y esperar triunfar en La Fortaleza.
“Primer objetivo no encajar el gol, cumplido, segundo objetivo no anotar gol, no cumplido.
Primeros noventa minutos no completamente satisfecho con el resultado, pero contento de no haber encajado el gol. Hay que recuperar a la gente. El partido ya empezó, lo fundamental es recuperarse, dormir y descansar, mañana cuando regresemos, preparar el equipo. Cada segundo cuenta, para trabajar y preparar el equipo desde ya”, compartió el timonel.
Sumado a ello, El Mago dijo que le agradó el orden y la perseverancia de sus pupilos, además resaltó que también hicieron un buen trabajo los elementos que ingresaron de cambio.
“Lo que me gustó más es el orden la per-
severancia de cumplir con el trabajo y el planteamiento, después los cambios que entraron lo hicieron bien. Tuvimos varias amarillas en la defensa y eso nos proporcionó tener que hacer cambios para contrarrestar a un equipo que iba por marcar el gol, con todo esto, me gustó la unión y determinación del grupo, hoy no encajamos, cumplimos y toca la otra parte del juego que es marcar y ganar. Todos pensaban que hoy se resolvería todo, estamos con un resultado que no digo que es fantástico pero es lo que nos da poder construir encima de esta actuación, vamos a estar listos para el domingo y no hay que dar mucha vuelta ni hablar”, finalizó.
domingo 28 de mayo del 2023
Gente
EL DIARIO DE CIUDAD VICTORIA EDITORA: VALERIA MALDONADO
REDACCIÓN
Desde hace unos días, tal vez semanas, se ha estado hablando mucho sobre los “startalents”. Aunque hay muchas opiniones relacionadas con esta palabra, la verdad es que muchos no saben muy bien a qué se hace referencia cuando se la menciona; también hay quienes la usan para referirse a una cosa que no es la correcta.
Y es que a pesar de que la palabra “startalent” empezó a ser más usada en el vocabulario general de las personas debido a la polémica que generó “Spider-Man: Across the Spider-Verse”, lo cierto es que el uso de startalents dentro de doblaje (principalmente para películas animadas) se ha hecho desde hace varios años atrás.
Una vez dicho esto, empecemos por aclarar: ¿qué son los startalet?… pues cuando hacemos uso de esta palabra nos estamos refiriendo a personalidades dentro del mundo del espectáculo (actores, comediantes, cantante) que cuentan con gran reconocimiento ya sea nacional o internacional y que son “llevados” al mundo del doblaje.

Dentro de esta categoría podemos mencionar a Euguenio Derbez prestando su voz para el personaje de Burro en las películas de “Shrek”, a Consuelo Duval como Elastigirl de “Los Increíbles” o Omar Chaparro que en esta misma película dio voz a Síndrome (Chaparro incluso logró convertirse en la voz de Po en la saga de “Kung Fu Panda).
Estos son solo algunos ejemplos, quizá, de algunos nombres que todo mexicano reconoce. Sin embargo, no son los únicos y la lista de famosos que han participado en el doblaje de alguna película de manera exitosa, incluso sorprendiendo al demostrar que son buenos haciendo doblaje, si bien no podemos decir que es extensa, sí es considerable.
Ahora, en tiempos más recien-
‘STARTALENT’ NO ES LO MISMO QUE INFLUENCER
(videojuegos, fitness, belleza).
¿Queremos decir que no se deberían usar influencers en el dobleaje?, no precisamente, y es que, como en todo, en este tema hay variables. Una cosa es tener a influencers con personajes que aparecen cinco minutos y otra muy diferente ponerlos en roles principales (como el caso de Luisito Comunica, que fue la voz de Sonic), situaciones en donde se nota la falta de preparación por parte de quienes prestan su voz.
Por otro lado, están las personas a las que no les interesa cómo suena un personaje o que tan capaz es alguien de transmitir emociones a través de solo entonaciones de su voz, personas que solo van a ver una película porque quieren divertirse sin analizar o sobrepensar lo que se está contando de manera indirecta; entonces genuinamente no tienen interés en si hay un profesional, un startalent o un influencer en el doblaje.
¿Queremos decir que el doblaje es solo para profesionales?, tal vez (éticamente) esto sea lo que debería de suceder siempre, aunque honestamente el sector al que le interesa (y conoce) sobre el doblaje es uno muy reducido. Fuera de ese círculo, a la mayoría de las personas les es indiferente si en una película estará Mario Castañeda, Rossy Aguirre o Carlos Segundo. Es decir, no van a comprar un boleto por el hecho de que haya buenos actores de doblaje.
APROVECHANDO UN POCO LA POLÉMICA QUE HAY EN REDES SOCIALES SOBRE ESTE TEMA, TE COMPARTO MI OPINIÓN
tes la palabra “startalent” se empezó a usar también para referirse a influencers o youtubers que eran contratados para sumarse al doblaje. Y aunque no es un pecado que las compañías busquen la manera de atraer a más público a
MUCHO ROSA EN NUEVO AVANCE
AGENCIAS
La cinta “Barbie” estrenó en días pasados el nuevo tráiler de la que será su nueva adaptación, revelando más detalles y nuevos vistazos de los personajes. Más rosa que nunca, la película muestra lo que será el mundo donde se desarrolla la historia, así como las diferentes versiones de Barbie y Ken que habrá en la película.
Además, este nuevo adelanto muestra más detalles de la trama, con un vistazo a la aventura que tendrán Barbie y Ken en el mundo real, adelantando que no toda la película se desarrollará en “Bar-
bieland” sino que nuestros protagonistas darán el salto al mundo actual, donde se enfrentarán a diferentes situaciones.
El tráiler presenta a un mundo perfecto donde Barbie y sus amigas disfrutan de una vida llena de fantasía y mucho color rosa. Sin embargo, Barbie comienza a experimentar una “crisis existencial” al preguntarse sobre la muerte. A raíz de esto comenzará a tener algunos tropiezos en el mundo de “Barbieland”.
Eso la lleva a pedirle ayuda a la Barbie interpretada por Kate McKinnon, quien le responde que
las salas de cine, la verdad es que las probabilidades de que estas personalidades hagan un buen trabajo no son muy altas.
Entonces con este contexto básico podemos definir que sí hay una diferencia entre el uso de
startalents y el uso de ifluencers dentro del doblaje, y es que por un lado se habla de personas que tienen una carrera afín y seguramente más preparación; mientras que por otro se habla de personas que se desarrollan en otros intereses
¿A dónde queremos llegar con esto?… primero al hecho de señalar que no es lo mismo un startalent y un influencer/youtuber, ambos son usados para el mismo propósito solo que los diferencia la trayectoria y preparación dentro del medio. Segundo, que dentro del mundo del entretenimiento hay espacio para todos y por último… ¿por qué no darle una oportunidad al producto (o sea, a la película) antes de criticar la presencia de influencers?

debe elegir entre volver a su vida normal o ir al mundo real para “descubrir la verdad sobre el universo”. Barbie en compañía de Ken se adentran en una aventura para descubrir su propósito por lo que viajan al mundo real.
Sin embargo, no todo es cómo se lo imaginaban pues al llegar tendrán que enfrentarse a otra amenaza, donde un empresario querrá capturarla por miedo a que cause alguna catástrofe. Este nuevo tráiler nos acerca un poco más
a la trama que protagonizará Margot Robbie junto a Ryan Gosling; el filme dirigido por Greta Gerwig llegará a los cines de México hasta el 20 de julio, pero ya se está empezando la fuerte campaña promocional.

DOMINGO 28 DE MAYO DEL 2023